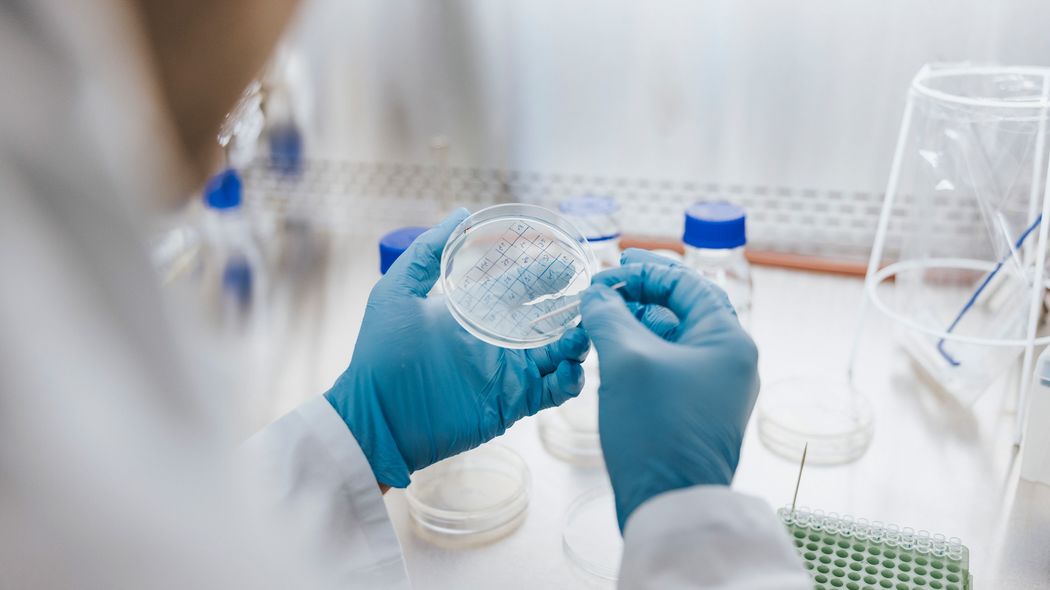
がん細胞をウイルス感染させ死滅させる…乳がんが再発した50歳ウイルス学者が行った驚きの｢自己実験｣ 倫理的問題はあるが医学の発展に寄与

新しい「腫瘍溶解性ウイルス療法」
2024年8月、『Vaccines』という医学雑誌に「再発性乳がんに対する術前腫瘍溶解性ウイルス療法の異例の症例研究」という論文が掲載されました(※1)。この論文は、一人の女性患者(50歳)の症例報告をまとめたものです。彼女は4年前に乳がんの治療を受けたものの、局所再発を起こしました。そこで「腫瘍溶解性ウイルス療法」という、特殊なウイルスを腫瘍に直接投与し、がん細胞を感染させて破壊し、免疫反応を誘導するという新しい治療法を受けたのです。なお、実際に使用されたウイルスは、弱毒化した麻疹ウイルスと水疱性口内炎ウイルスでした。
この治療を受けた結果、腫瘍のサイズは大幅に縮小しました。副作用は、最初のウイルス投与による発熱と悪寒がありましたが、たった3日で完全に消失。その後、外科手術によってがん組織が切除され、加えて標準的な術後補助化学療法が行われました。論文が書かれた治療開始から45カ月後の時点では、再発は認められていません。切除されたがん組織には強いリンパ球浸潤が認められ、がん細胞に対する免疫反応が誘導されたことが示唆されました。
ただし、現時点では、この治療法には十分なエビデンスがあるとはいえず、実験段階です。乳がんに対してもいくつか臨床試験が行われているものの、どのようなウイルスをどのタイミングで使うべきなのか、ほぼわかっていません。
※1 An Unconventional Case Study of Neoadjuvant Oncolytic Virotherapy for Recurrent Breast Cancer. Vaccines (Basel). 2024 Aug 23;12(9):958.
心臓カテーテルも「自己実験」から
新しい治療法の症例報告はめずらしくありませんが、この論文には他と一線を画す特筆すべき点があります。それは、この患者がウイルス学者であり、自身の研究室で調製したウイルスを治療に使用したところです。つまり、自分の体を使って実験する、いわば「自己実験」だったのです。
医学の歴史には、しばしば自己実験が登場します。特に有名な例は、世界で初めて人間の心臓にカテーテルを挿入してレントゲン写真を撮影したドイツの医師、ヴェルナー・フォルスマンによる自己実験です。今からおよそ100年前の1929年、フォルスマン(当時25歳)は、自らの左肘の静脈からカテーテルを入れ、心臓に達した様子をレントゲン写真で撮影しました。もちろん、当時は心臓用のカテーテルなんてありませんから、ゴム製の尿管カテーテルを使用したのです。
いきなり患者さんに行うのは危険なので、やむなく自分の体で試したのでしょう。この無謀ともいえる実験は上司からの評判が悪く、フォルスマンは研究生活を離れ、開業医になりました。しかし、自己実験から約30年後の1956年、心臓カテーテル法を確立させた2人の医学者とともに、フォルスマンはノーベル生理学・医学賞を受賞しました。現在では心臓カテーテル法は心臓病の診療に欠かせない技術であり、冠動脈の狭窄の有無や程度を診断する検査「冠動脈造影」、狭くなった冠動脈を広げる治療などに応用され、たくさんの患者さんの命を救っています。